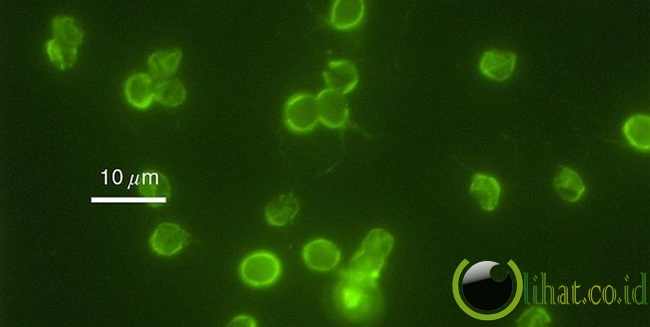

[lihat.co.id] - Semua air sebenarnya memiliki bakteri dan protozoa, dan memang ada sebagian besar dari mereka benar-benar berbahaya jika sudah melebihi ambang batas tertentu. Berikut adalah 10 mikroorganisme yang dapat hidup di air minum, dikutip dari berbagai Sumber:
10. Cryptosporidium
10. Cryptosporidium
[lihat.co.id] - Cryptosporidium adalah protozoa patogen dari divisi Apicomplexa dan menyebabkan penyakit diare yang disebut cryptosporidiosis. Jenis Apicomplexan patogen lainnya yaitu parasit Plasmodium (malaria) dan Toxoplasma (toksoplasmosis).
Tidak seperti Plasmodium, yang penularannya melalui vektor nyamuk, Cryptosporidium tidak memanfaatkan seekor serangga vektor pun dan mampu menyelesaikan siklus hidupnya dalam satu host, sehingga cysta-nya dikeluarkan bersamaan dengan kotoran dan mampu menular ke host baru.
9. Anabaena sp
[lihat.co.id] - Anabaena adalah genus cyanobakteria filamentous atau ganggang hijau-biru,ditemukan sebagai plankton. Anabaena diketahui berperan dalam menfiksasi nitrogen, dan Anabaena membentuk hubungan simbiosis dengan tanaman tertentu seperti pakupakuan. terdapat satu dari 4 genera dari cyanobacteria yang menghasilkan neurotoxin,yang membahayakan margasatwa lokal seperti halnya hewan ternak dan hewan peliharaan. Spesies tertentu dari Anabaena telah digunakan dalam pertanaman padi sawah, sebagai penyedia pupuk alami yang efektif.
8. Rotifers
[lihat.co.id] - Rotifers adalah hewan mikroskopis dari divisi Rotifera. Rotifers dapat ditemukan di berbagai lingkungan dan air tawar. Rotifers juga sering ditemui pada mosses dan lichens tumbuh pada batang pohon dan batu.
Merupakan binatang kosmopolitan.
- Banyak terdapat di air tawar
- Dikenal sebagai wheel animacules (binatang beroda).
- Ukuran 40 mikrometer � 2.5 mm, rata- rata 200 mikrometer.
- Hidup soliter, berkoloni, dan sesil.
- Tubuh transparan, warna disebabkan warna saluran pencernaan (hijau, merah, dan coklat).
7. Copepods
[lihat.co.id] - Copepoda adalah grup crustacea kecil yang dapat ditemui di laut dan hampir di semua habitat air tawar dan mereka membentuk sumber terbesar protein di samudra. Banyak spesies adalah plankton, tetapi banyak juga spesies benthos dan beberapa spesies kontinental dapat hidup di habitat limno-terestrial dan lainnya di tempat terestrial basah, seperti rawa-rawa.
6. E. Coli
[lihat.co.id] - Escherichia coli adalah salah satu jenis bakteri yang secara normal hidup dalam saluran pencernaan baik manusia maupun hewan yang sehat. Nama bakteri ini diambil dari nama seorang bacteriologist yang berasal dari Germani yaitu THEODOR VON ESCHERICH, yang berhasil melakukan isolasi bakteri ini pertama kali pada tahun 1885. DR. ESCHERICH juga berhasil membuktikan bahwa diare dan gastroenteritis yang terjadi pada infant adalah disebabkan oleh bakteri Escherichia coli.
5. Rhizopus stolonifer
[lihat.co.id] - Rhizopus stolonifer merupakan salah satu dari jenis jamur Zygomycotina. Jenis jamur ini memiliki hifa pendek bercabang-cabang dan berfungsi sebagai akar (rizoid) untuk melekatkan diri serta menyerap zat-zat yang diperlukan dari substrat. Selain itu, terdapat pula sporangiofor (hifa yang mencuat ke udara dan mengandung banyak inti sel, di bagian ujungnya terbentuk sporangium (sebagai penghasil spora), serta terdapat stolon (hifa yang berdiameter lebih besar daripada rizoid dan sporangiofor).
4. Naegleria fowleri
[lihat.co.id] - Naegleria fowleri dikenal dengan karakteristik yang disebut amebaflagellata, yaitu memiliki bentuk ameboiddan flagellata dalam hidupnya. Siklus hidupnya terdiri atas stadium trophozoit (ameboid dan flagellata) yang motile dan bentuk kista yang non-motile dan resisten. Trophozoit bentuk ameboid adalah bentuk satu-satunya yang dijumpai pada manusia.
3. Legionella Pneumophila
[lihat.co.id] - Legionella pneumophila termasuk bakteri Gram negatif, berbentuk batang, tidak meragi D-glukosa, tidak mereduksi nitrat menjadi nitrit. Koloni bakteri ini hidup subur menempel di pipa-pipa karet dan plastik yang berlumut dan tahan kaporit dengan konsentrasi klorin 2�6 mg/l. Legionella dapat hidup pada suhu antara 5,7�C - 63�C dan hidup subur pada suhu 30�C - 45�C.
2. Chaetomium sp
[lihat.co.id] - Chaetomium sp. spora tidak terlalu berbahaya, meskipun dalam beberapa kasus mereka dapat menyebabkan infeksi yang dikenal sebagai phaeohyphomycosis, yang merupakan sesuatu yang Anda pasti tidak ingin Googling. Mereka juga dapat menimbulkan bahaya bagi orang yang alergi terhadap spora, dan bahkan yang biasanya hanya terjadi dengan paparan kronis.
1. Salmonella Enterica
[lihat.co.id] - Salmonella adalah suatu genus bakteri yang merupakan penyebab utama penyakit bawaan makanan di seluruh dunia. Bakteri umumnya ditularkan ke manusia melalui konsumsi makanan yang terkontaminasi yang berasal dari hewan, terutama daging, unggas, telur dan susu.

0 comments